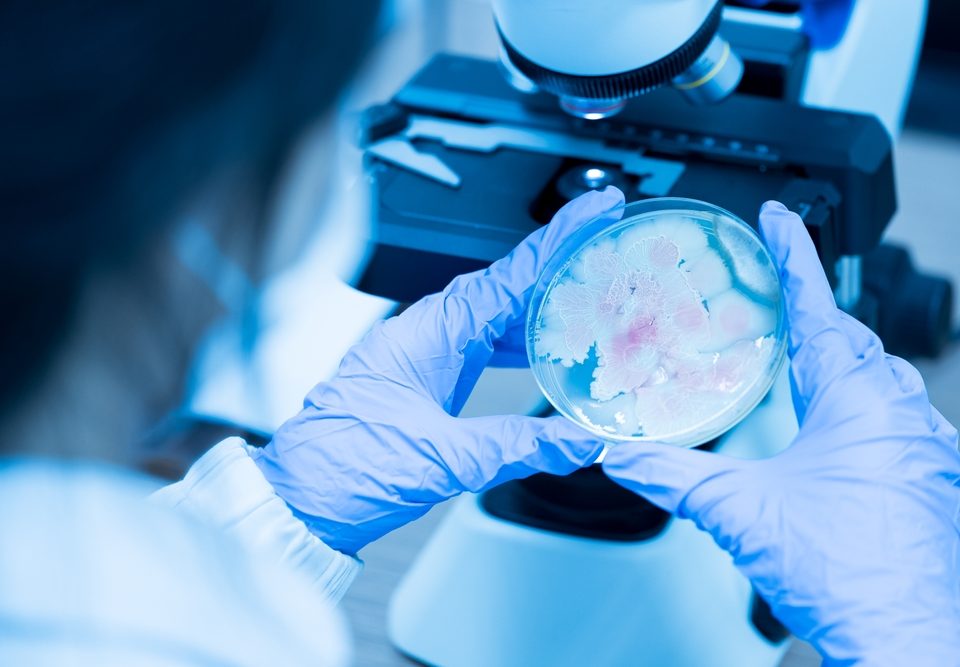

Środek biobójczy bez tajemnic - blog
27 March 2025
Plan zatwierdzeń substancji czynnych to kluczowy element regulacji unijnych, obejmujący harmonogram oceny substancji aktywnych wykorzystywanych w produktach biobójczych. Plan ten ma na celu kontrolę i bezpieczeństwo […]
17 February 2025
Produkty biobójcze odgrywają kluczową rolę w zapewnieniu higieny i bezpieczeństwa w wielu aspektach codziennego życia. Ich działanie jest niezbędne do walki z mikroorganizmami, które mogą stanowić […]
17 February 2025
W dobie rosnącej świadomości na temat higieny i bezpieczeństwa produkty biobójcze zyskują na znaczeniu. Są niezbędne w wielu sektorach, od medycyny przez przemysł aż po codzienne […]